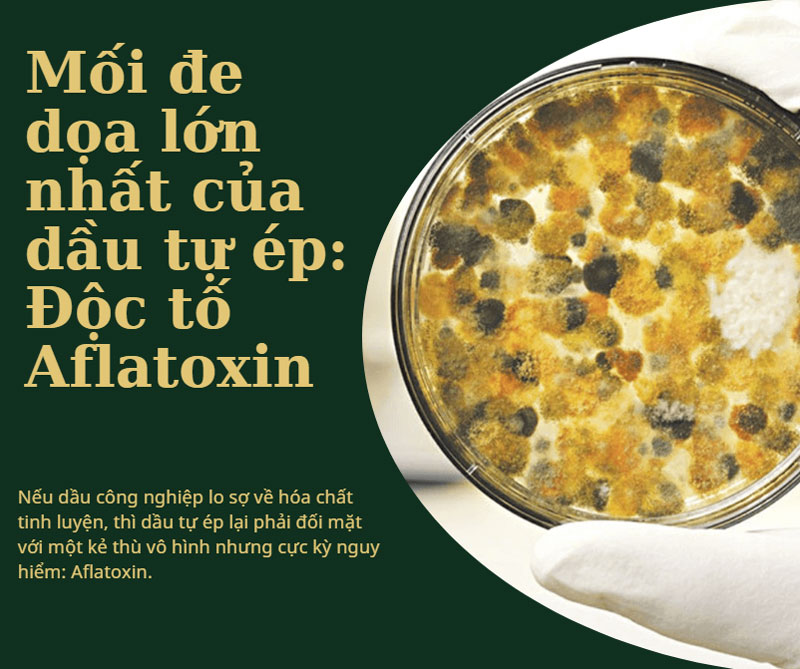
Mối đe dọa lớn nhất của dầu tự ép: Độc tố Aflatoxin

Xu hướng tự ép dầu thực vật tại nhà đang được nhiều gia đình lựa chọn với niềm tin rằng dầu “tự làm” sẽ sạch và tốt cho sức khỏe hơn dầu mua sẵn. Tuy nhiên, ít ai biết rằng nếu không hiểu rõ về nguyên liệu, nhiệt độ ép, thiết bị sử dụng và cách bảo quản, dầu thực vật tự ép có thể tiềm ẩn nhiều rủi ro cho sức khỏe. Trước khi đưa loại dầu này vào bữa ăn hàng ngày, có một số điều quan trọng bạn nhất định phải biết.

Sử dụng dầu thực vật tự ép có tốt không?
Nếu dầu công nghiệp lo sợ về hóa chất tinh luyện, thì dầu tự ép lại phải đối mặt với một kẻ thù vô hình nhưng cực kỳ nguy hiểm: Aflatoxin.
Aflatoxin là một loại độc tố vi nấm (mycotoxin) được sản sinh bởi một số chủng nấm mốc thuộc chi Aspergillus (chủ yếu là Aspergillus flavus và Aspergillus parasiticus).
- Nơi cư ngụ: Loại nấm mốc này đặc biệt ưa thích các loại hạt có dầu như lạc (đậu phộng), ngô, hạt óc chó, hạt dẻ, và các loại ngũ cốc nếu chúng được lưu trữ trong điều kiện ẩm thấp, nóng ẩm và kém thông thoáng.
- Đặc tính nguy hiểm: Aflatoxin là một trong những chất gây ung thư mạnh nhất được biết đến, đặc biệt nhắm vào gan. Nó có khả năng tích lũy dần dần trong cơ thể, gây xơ gan, suy gan và ung thư gan.
Quá trình ép dầu tại nhà thường là ép lạnh hoặc ép nóng nhẹ (dưới 120 độ C).
- Đánh giá: Nhiệt độ ép dầu này KHÔNG ĐỦ để tiêu diệt hoặc phân hủy hoàn toàn độc tố Aflatoxin. Aflatoxin rất bền với nhiệt, cần nhiệt độ rất cao (trên 250 độ C) mới có thể bị phá hủy.
- Hệ quả: Nếu bạn sử dụng lạc, vừng, hay đậu nành đã bị nấm mốc và nhiễm Aflatoxin để ép, độc tố này sẽ thôi nhiễm trực tiếp vào dầu thành phẩm. Dầu ép ra dù có vẻ ngoài trong và thơm, nhưng đã mang mầm bệnh nguy hiểm.
Độc tố Aflatoxin không bị loại bỏ hoàn toàn qua quá trình lọc thông thường của máy ép dầu gia đình. Sự nguy hiểm của Aflatoxin trong dầu tự ép chính là lý do tại sao bạn không nên ăn dầu tự ép nếu không biết cách chọn nguyên liệu.
Aflatoxin kẻ thù tiềm ẩn trong hạt thực vật
Mấu chốt để sử dụng dầu tự ép an toàn nằm ở bước đầu tiên: Lựa chọn và xử lý nguyên liệu.
*** Không ẩm (độ ẩm lý tưởng dưới 8%)
Độ ẩm là điều kiện tiên quyết cho nấm mốc phát triển. Hạt nguyên liệu như lạc cần được sấy khô hoặc phơi khô kỹ lưỡng trước khi ép.
Hạt phải giòn, bẻ đôi dễ dàng, không có cảm giác dính hoặc mềm.
*** Không mốc (Loại bỏ triệt để các hạt có dấu hiệu biến chất)
Bất kỳ hạt nào có dấu hiệu nấm mốc màu xanh, vàng hoặc xám đều phải bị loại bỏ ngay lập tức. Độc tố Aflatoxin thường tập trung ở những hạt bị mốc, sâu bệnh hoặc đã chuyển màu.
Cần sàng lọc và lựa chọn bằng tay từng hạt để đảm bảo không một hạt mốc nào lọt vào máy ép.
*** Không hư hỏng (nguồn gốc rõ ràng)
Chỉ sử dụng hạt tươi, chất lượng cao, có nguồn gốc rõ ràng, được thu hoạch và bảo quản đúng cách (tốt nhất là hạt vừa thu hoạch và được sấy khô). Tuyệt đối không sử dụng hạt đã để lâu ngày, có mùi lạ hoặc mua trôi nổi.
Nhiều người thích rang sơ nguyên liệu (như lạc) trước khi ép để tăng hương vị và diệt một số vi khuẩn bề mặt. Tuy nhiên, việc rang này chỉ cải thiện mùi vị chứ không tiêu diệt được Aflatoxin nếu độc tố đã tồn tại trong nhân hạt.
Nếu rang, cần rang ở nhiệt độ vừa phải để tránh làm biến chất các axit béo, mất đi giá trị dinh dưỡng của dầu.

Kiểm soát nguyên liệu như thế nào để đảm bảo chất lượng dầu tốt?
Bên cạnh nguyên liệu, việc sở hữu một chiếc máy ép dầu lạc chất lượng cao là cần thiết để giảm thiểu rủi ro thôi nhiễm và đảm bảo vệ sinh.
Máy ép dầu phải có bộ phận tiếp xúc với dầu (trục ép, buồng ép) làm từ Inox 304 Food Grade. Điều này đảm bảo dầu không bị thôi nhiễm kim loại nặng do ăn mòn trong suốt quá trình hoạt động.
Inox 304 bền bỉ, chống ăn mòn bởi axit béo, dễ dàng vệ sinh, ngăn ngừa sự tích tụ cặn bẩn và vi khuẩn – yếu tố gián tiếp gây nấm mốc và mất an toàn vệ sinh.
Một chiếc máy ép dầu hạt chuẩn cần có các tính năng sau:
*** Hệ thống ép kín và dễ tháo lắp vệ sinh
- Chức năng: Trục ép và buồng ép phải được thiết kế để dễ dàng tháo rời và làm sạch sau mỗi lần sử dụng.
- Lợi ích: Loại bỏ triệt để cặn dầu thừa, ngăn chặn sự hình thành môi trường ẩm ướt, dính bẩn – nơi vi khuẩn và nấm mốc có thể sinh sôi, làm lây nhiễm chéo cho mẻ dầu tiếp theo.
*** Kiểm soát nhiệt chính xác (nếu ép nóng nhẹ)
Nhiệt độ ép được kiểm soát tự động. Để đảm bảo dầu được ép ra hiệu quả mà vẫn giữ nguyên tối đa các Vitamin E và khoáng chất, đồng thời tránh quá nhiệt làm biến đổi chất lượng dầu (quá nhiệt có thể tạo ra các hợp chất có hại khác).
Để xóa bỏ mọi nghi ngại về chất lượng thiết bị, người tiêu dùng nên tìm đến các nhà cung cấp uy tín, cam kết rõ ràng về vật liệu.
- Đảm bảo vật liệu: Các dòng máy ép dầu thực vật tại Siêu Thị Hải Minh (cả gia đình và công nghiệp) đều được cam kết sử dụng Inox 304 tiêu chuẩn.
- Tư vấn chuyên sâu: Đội ngũ chuyên gia không chỉ bán máy mà còn tư vấn kỹ lưỡng về quy trình lựa chọn và xử lý nguyên liệu để đối phó với mối nguy hiểm Aflatoxin.
*** Các bước kiểm tra máy trước khi mua
- Kiểm tra trục và buồng ép: Yêu cầu xác nhận vật liệu là Inox 304, bề mặt phải sáng bóng, nhẵn mịn.
- Kiểm tra khả năng vệ sinh: Thử tháo lắp các bộ phận tiếp xúc với dầu để đảm bảo việc làm sạch sau này là dễ dàng.
- Xem xét bảo hành: Chính sách bảo hành tốt là minh chứng cho sự tự tin vào chất lượng sản phẩm.

Mua máy ép dầu inox 304 chính hãng tại sieuthihaiminh.vn
Dầu thực vật tự ép không xấu, nhưng chỉ thực sự an toàn khi người dùng hiểu rõ toàn bộ quy trình từ nguyên liệu, thiết bị, nhiệt độ ép cho đến cách bảo quản. Việc sử dụng dầu tự ép một cách cảm tính, thiếu kiến thức có thể khiến dầu bị biến chất, nhiễm tạp chất hoặc không còn giá trị dinh dưỡng như mong muốn. Trước khi đưa dầu tự ép vào bữa ăn hàng ngày, hãy chắc chắn rằng bạn biết rõ mình đang ăn gì, bởi sức khỏe lâu dài không nên đặt cược vào sự chủ quan.
==> Xem thêm: Top 10 máy ép dầu gia đình bán chạy nhất
Giữa hai phương pháp phổ biến là cắt bê tông khô và cắt bê tông bằng nước (cắt ướt), máy cắt bê tông bằng nước ngày càng được nhiều nhà thầu, đơn vị thi công ưu tiên. Vậy máy cắt bê tông bằng nước có ưu điểm gì so với cắt khô?
Lắp âm sàn cho máy quấn màng pallet giúp tối ưu không gian, tăng hiệu quả vận hành. Khám phá ưu nhược điểm chi tiết trước khi lựa chọn.
Bạn đang cần pa lăng để nâng hạ nhưng sợ chọn nhầm loại, mua sai tải trọng, khó dùng,… Thực tế, rất nhiều người mới hoang mang khi mua lần đầu. Bài viết này sẽ giúp bạn biết cách chọn đúng loại cho nhu cầu và tránh những sai lầm tốn kém.
Vì sao dùng máy đầm bê tông nhưng bê tông vẫn bị rỗ? Nguyên nhân do đâu: do thiết bị, kỹ thuật vận hành hay chất lượng vật liệu? Bài viết dưới đây sẽ phân tích chi tiết các nguyên nhân thường gặp và cách khắc phục hiệu quả
Vận hành máy đột lỗ kim loại MHP-20 an toàn không khó nếu nắm vững kỹ thuật. Khám phá cách dùng máy đột lỗ cầm tay chuẩn xác. Xem ngay bí quyết giúp máy đục lỗ bền bỉ từ chuyên gia!
"Mua máy co màng ở đâu chất lượng?" trở thành nỗi trăn trở của nhiều chủ doanh nghiệp. Bài viết này sẽ phân tích các tiêu chí lựa chọn và gợi ý địa chỉ mua đầu tư uy tín nhất hiện nay.